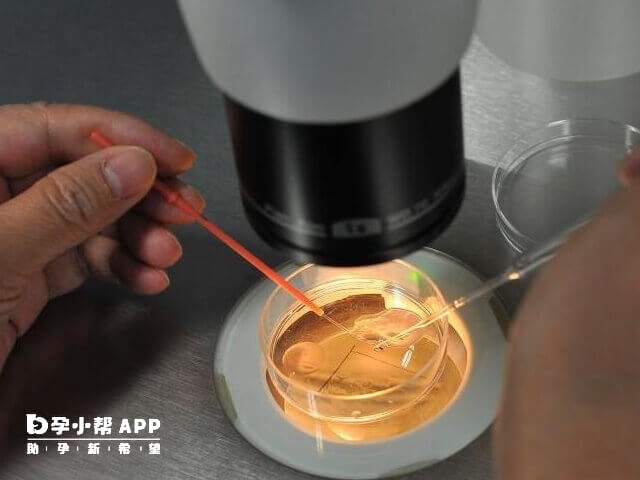
桑葚胚胎介于卵裂期胚胎和囊胚之间的胚胎

桑葚胚胎介于卵裂期胚胎和囊胚之间的胚胎,具有较高的发育潜力,因此移植的成功率也是比较高的,大概在40%-60%左右,部分研究显示可达50%左右。若患者无法获得囊胚,桑葚胚胎是较好的替代选择,不过要注意的是,移植桑椹胚的成功率还会因女性年龄、子宫环境和胚胎质量等多种因素而不同。
桑葚胚胎(桑葚胚)是胚胎发育过程中的一个重要阶段,通常出现在受精后的第4天左右。 桑葚胚由16-32个细胞组成,细胞紧密排列成实心球体,外观类似桑葚果实,此时细胞尚未开始分化,属于是受精卵到囊胚的过渡阶段,其前一阶段为受精卵分裂期,后一阶段为囊胚期。在辅助生殖技术(如试管婴儿)中,桑葚胚的发育质量直接影响后续囊胚形成及着床成功率。胚胎学家会通过观察细胞均一性、分裂速度等指标评估胚胎活性,筛选优质胚胎进行移植。
桑葚胚胎移植成功率一般在40%-60%左右,部分研究显示可达50%左右。相比普通胚胎,其发育潜能较好,细胞数量较多,更符合自然生理过程,因此成功率相对较高。不过要注意的是,影响移植桑椹胚的成功率因素还要:
1、女性年龄:年龄越大,成功率越低。35岁以下女性成功率相对较高,35岁以上可能降至30%左右;
2、子宫环境:子宫内膜厚度、形态及是否存在病变(如肌瘤、粘连等)直接影响胚胎着床。理想内膜厚度为8-12mm;
3、胚胎质量:桑葚胚胎本身质量较高,但若存在染色体异常或发育缺陷,仍可能影响成功率;
4、心态与生活习惯:长期焦虑、压力或不良生活习惯(如熬夜、吸烟)可能影响内分泌,降低成功率。
文章更新时间:2025-08-1413:44:03
位姐妹
高龄/绝经试管
助孕攻略群
位姐妹
不孕不育
助孕经验群
位姐妹
染色体异常
备孕交流群
位姐妹
三代/四代试管
助孕交流群